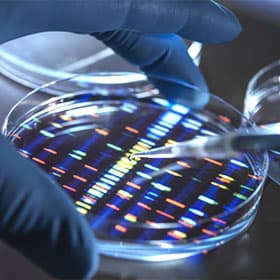
Teste Genético

Amplo atendimento a convênios
Aceitamos os principais convênios da região com atendimento personalizado e acolhedor.
Ambiente completo e acolhedor
Equipe capacitada e preparada para cuidar de você: psicologia, fonoaudiologia, terapia ocupacional, fisioterapia e nutrição.
Atendimento presencial ou telemedicina
Equipe multidisciplinar com profissionais altamente capacitados.
Quem somos
Cuidado integral em genética médica e autismo
Somos uma clínica especializada em genética médica e autismo. Possuímos um ambiente completo para diagnóstico, tratamento e acompanhamento do paciente nas mais diversas áreas da saúde, medicina, psicologia, terapia ocupacional, pedagogia, fonoaudiologia, nutrição, fisioterapia e coordenação do cuidado. Trabalhamos com ciência ABA e contraturno escolar.
Cobertura ampla
Aceitamos convênios e oferecemos atendimento acolhedor para diferentes necessidades.
Estrutura completa
Ambiente preparado com consultórios integrados e espaços terapêuticos especializados.
Profissionais especializados
Equipe multidisciplinar com foco em genética, autismo e terapias integradas.

Tratamentos
Nossos tratamentos e especialidades
Abordagem integrada com profissionais de diferentes áreas para cada etapa do cuidado.
Aconselhamento Genético
Verificar a probabilidade de uma doença genética ocorrer em uma família, orientando sobre riscos e medidas preventivas.

Coordenação de Cuidados
Acompanhamento multiprofissional completo para pessoas com condições especiais e doenças raras, centralizando todo o cuidado em um único lugar.

Fonoaudiólogo
Prevenção, avaliação, diagnóstico, orientação e reabilitação, estimulando e aperfeiçoando fala e audição.

Nutricionista
Avaliação, prescrição e orientação de dietas específicas para sua saúde ou qualidade de vida.

Psicólogo
Acompanhamento aos pacientes e familiares contribuindo para melhora clínica e apoio social.

Pedagogo
Atua em processos de ensino e aprendizagem como apoio educacional para crianças e adolescentes.

Fisioterapeuta
Avalia lesões e aplica tratamentos físicos baseados em diagnóstico funcional para reabilitação e qualidade de vida.

Terapeuta Ocupacional
Ensina e apoia atividades de vida diária, proporcionando autonomia e qualidade de vida ao paciente.

Teste Genético
Analisa alterações no DNA para verificar a probabilidade de desenvolver determinada condição ou doença genética.

Prevenção de Doenças
Adotar hábitos saudáveis e medidas preventivas para reduzir a manifestação de doenças hereditárias e genéticas.

Farmacogenômica
Descobrir quais medicamentos possuem melhor aceitação pelo seu corpo, personalizando o tratamento farmacológico.

Autismo
Especialização em diagnóstico e acompanhamento do TEA
Cuidados especiais para pessoas com autismo — Consulta inicial, solicitação e coleta de exames quando necessário (para afastar síndromes ou doenças raras) e indicação para especialidades certas, além de acompanhamento de consultas e evolução feito por médico. Tudo isso centralizado em um mesmo ambiente! O diagnóstico na idade adulta também pode ser realizado. Perde-se a 'janela de oportunidade' da neuroplasticidade, mas isso não quer dizer que o adulto não tenha opções terapêuticas, em especial nos campos em que apresenta mais dificuldade.
O diagnóstico pode ocorrer na infância ou na idade adulta, com acolhimento e orientação completa.
Profissionais envolvidos
- Médicos geneticistas e pediatras
- Psicólogos e psicopedagogos
- Fonoaudiólogos especializados
- Terapeutas ocupacionais
- Fisioterapeutas
- Nutricionistas
- Nutrólogo
- Psiquiatra
Convênios e Planos
Amplo atendimento a convênios












Equipe
Nossos profissionais
Dúvidas frequentes
Perguntas sobre genética e autismo
É o especialista em diagnosticar, acompanhar e tratar as doenças de causas genéticas, sendo elas hereditárias ou não. Ele investiga a história clínica do paciente e da família para indicar os melhores exames e tratamentos.
Pessoas com malformações congênitas; crianças com autismo, déficit intelectual ou atraso em desenvolvimento; casais com perdas gestacionais recorrentes; histórico de câncer em idade jovem ou suspeita de câncer hereditário; ou qualquer suspeita de condição genética.
Depende de cada caso. Acima de tudo deve-se fazer um levantamento da história clínica e exame físico detalhado a fim de indicar o melhor exame genético. Entre os exames mais comuns estão: cariótipo, CGH-array, painéis genéticos e sequenciamento do exoma.
Com o crescimento da medicina genética, foi possível mapear toda a informação hereditária de um organismo em seu DNA. A maior arma que temos contra as doenças genéticas é o diagnóstico precoce, permitindo intervenções mais eficazes e melhor qualidade de vida.
É um exame simples para o paciente, bastando apenas que ele forneça uma amostra de sangue ou saliva. Por meio de técnicas de laboratório específicas e modernas, o DNA desta amostra é isolado e devidamente sequenciado para análise.
O autismo é um distúrbio neurológico que se encaixa no Transtorno do Espectro Autista (TEA). A maioria das pessoas com autismo possuem dificuldades na reciprocidade socioemocional, comportamentos comunicativos não verbais e na interação social.
As causas não são totalmente conhecidas. A pesquisa concentrou esforços no estudo da predisposição genética, analisando mutações espontâneas e herança genética. Já há evidências de que causas hereditárias explicariam apenas metade do risco, sendo fatores ambientais também relevantes.
Desenvolvimento diferente do esperado para a faixa etária: demora para começar a falar, evitar contato visual, não atender ao chamado do nome, não apontar, não brincar com crianças da idade, não brincar de faz de conta, dificuldade com linguagem figurada, brincar com brinquedos de maneira incomum, maior interesse por objetos do que pessoas, movimentos repetitivos, sensibilidade a sons e não gostar de toque.
Sim, existem diferentes graus. O DSM-5 rotula os distúrbios como espectro justamente por se manifestarem em diferentes níveis de intensidade: alta funcionalidade (prejuízos leves), média funcionalidade (menor independência) e baixa funcionalidade (dificuldades graves que exigem apoio substancial).
O diagnóstico é clínico — não existe exame laboratorial ou de imagem que possa comprovar. Deve ser realizado por profissional médico especializado, seguindo critérios internacionais, com avaliação completa, entrevista com pais e cuidadores e escalas validadas.
Programa ABA
Programa ABA para crianças autistas de 2 a 12 anos
Programa de Acompanhamento ABA — Oferecemos o suporte necessário para crianças autistas e suas famílias. Atendemos crianças autistas de 2 a 12 anos nos turnos matutino (7h30-12h30) e vespertino (13h-18h). Equipe especializada em autismo com acompanhamento ABA de excelência, contrato semestral e documentação completa. Usamos amplamente a terapia ABA para tratamentos em segmentos como psicologia, pedagogia, fonoaudiologia e terapia ocupacional.
Resultados esperados
Blog
Conteúdos e novidades

Julho Verde: Campanha Nacional de prevenção
O Julho Verde traz consigo uma importante mensagem de conscientização: a prevenção é a melhor forma de combater o câncer.
Leia mais
Dia do Oncologista: Vamos homenagear esses profissionais
O Dia do Oncologista é uma oportunidade de agradecer a esses profissionais dedicados e também de conscientizar sobre a prevenção.
Leia mais
O significado por trás do Cordão Girassol
Você já se perguntou o que significa quando alguém usa o Cordão Girassol? Esse objeto tem um papel fundamental na inclusão.
Leia maisDepoimentos
Histórias de quem confia no Instituto
Galeria
Ambiente acolhedor e completo
Fale com nossa equipe
Estamos prontos para orientar e acolher você. Entre em contato pelo WhatsApp ou email.